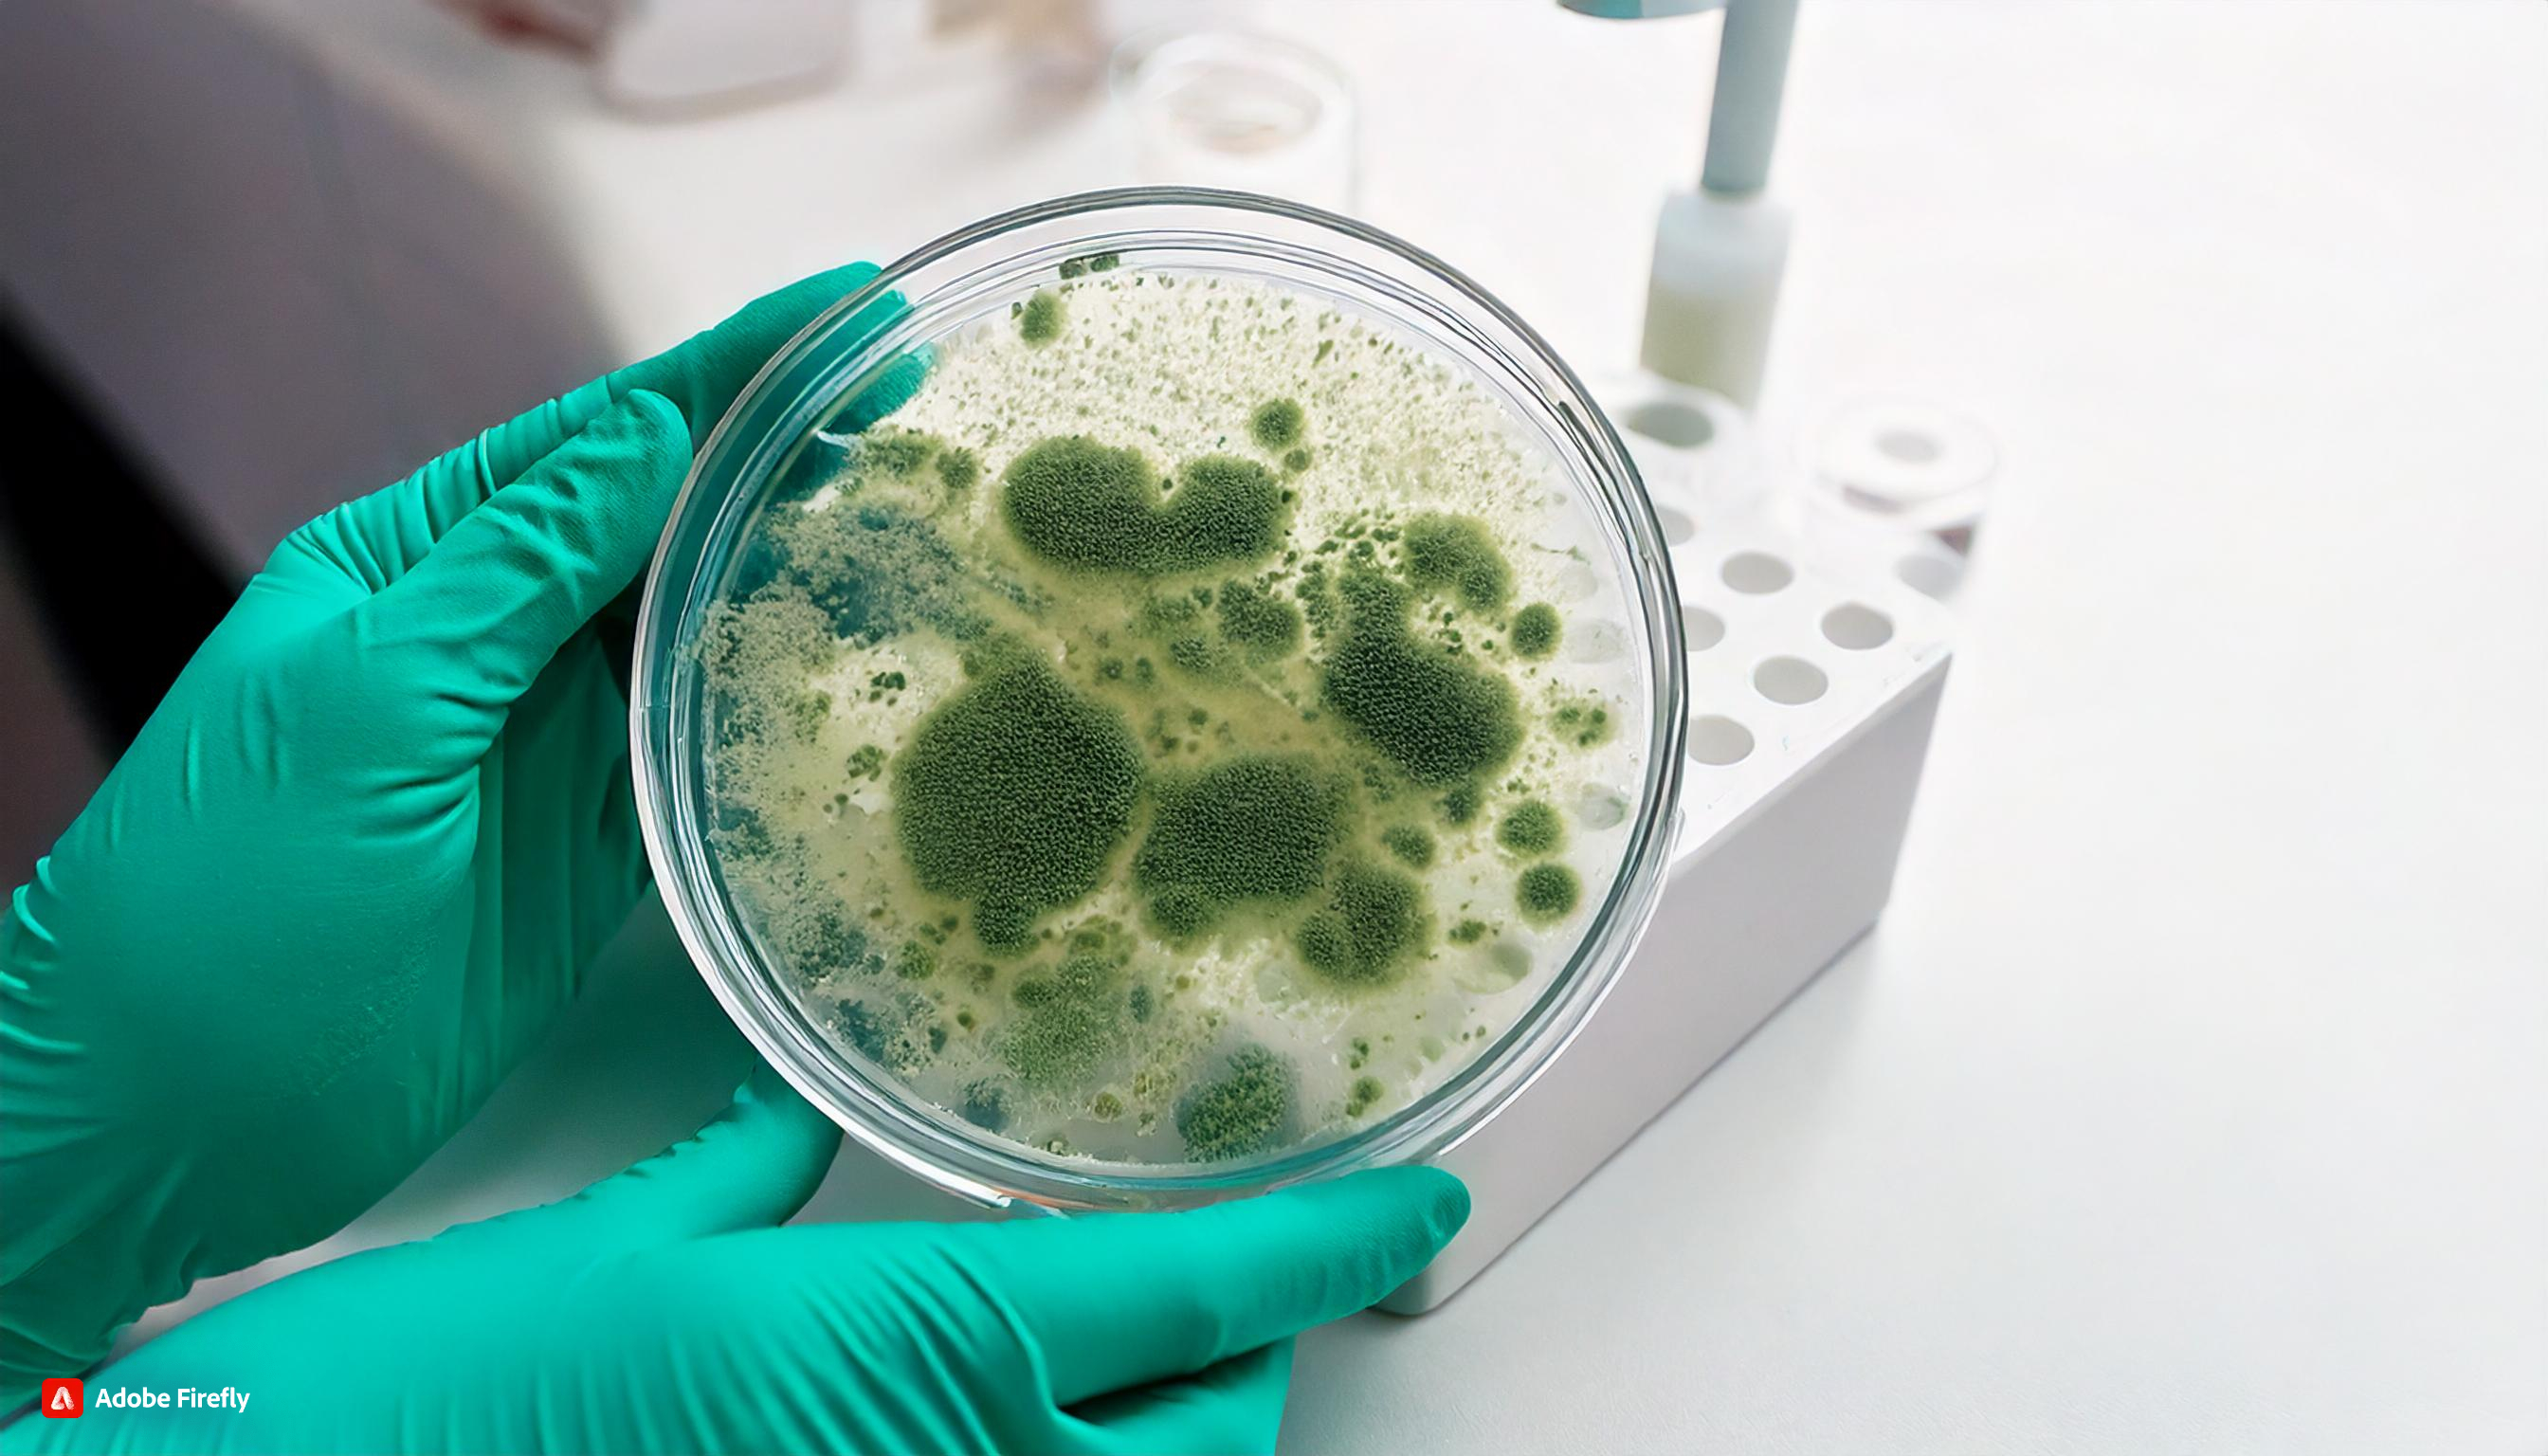

Комплексное исследование причин возникновения плесени
Точная диагностика. Обоснованные выводы. Эффективные решения.
| Появление плесени в помещении — тревожный сигнал о нарушении микроклимата, строительных дефектах или проблемах с вентиляцией. Плесневые грибы не только разрушают отделку и конструкции, но и несут серьёзную угрозу здоровью: могут вызывать аллергию, заболевания дыхательных путей, кожные реакции и даже интоксикации. |  |
Наша услуга — это комплексное исследование, направленное на выявление всех факторов, которые привели к появлению грибка, с последующей выдачей профессионального заключения и рекомендаций.
Что включает комплексное исследование:
✅ Микробиологический анализ
| Отбор проб воздуха и с поверхностей (стены, потолки, мебель) |  |
|---|---|
| Определение наличия и концентрации спор плесени и грибков |  |
| Идентификация видов плесени и оценка их токсичности/аллергенности | |
✅ Оценка микроклимата в помещении
Поддержание правильного микроклимата в помещении — ключевое условие для предотвращения появления плесени и сохранения здоровья людей. Мы проводим профессиональные измерения параметров воздуха и поверхностей с оценкой их соответствия действующим санитарно-гигиеническим нормам.
✅ Температуру воздуха в помещенииСогласно гигиеническим требованиям для жилых помещений рекомендуется |  |
✅ Относительную влажность воздухаОптимальные показатели: |  |
✅ Кратность воздухообменаСогласно гигиеническим рекомендациям для жилых помещений: |  |
Выявление зон с повышенной конденсацией и риском образования плесени (в соответствии с гигиеническими нормами) Образование конденсата — основной фактор развития плесени в жилых и коммерческих помещениях. Повышенная влажность на поверхностях создаёт идеальную среду для роста грибков и бактерий. Мы проводим профессиональную диагностику участков с повышенным риском конденсации с оценкой соответствия санитарно-гигиеническим требованиям. |  |
✅ Инструментальное обследование конструкций
- Использование тепловизора для поиска скрытых мостиков холода
- Поиск участков повышенной влажности внутри стен и перекрытий
- Анализ гидроизоляции и целостности строительных материалов
✅ Анализ эксплуатационных и строительных причин
- Проверка герметичности окон и дверей
- Оценка состояния кровли, фасада, подвала
- Анализ возможных протечек, залива, некачественного ремонта
В результате вы получите:
- Полный технический отчёт с фотофиксацией и объяснением выявленных причин
- Микробиологическое заключение с классификацией плесени и оценкой рисков для здоровья
- Рекомендации по устранению плесени и предотвращению её повторного появления
- Советы по улучшению микроклимата, вентиляции и теплоизоляции
Где актуальна услуга:
- Квартиры и частные дома
- Офисные помещения
- Школы, детские сады, медицинские учреждения
- Объекты на стадии приёмки или капитального ремонта
Почему выбирают нас:
- Работаем с сертифицированной лабораторией
- Используем профессиональное оборудование (тепловизоры, влагомеры, микроскопы)
- Даём обоснованные рекомендации, не навязывая ненужные услуги
- Опытные микологи, экологи и инженеры в составе команды
Стоимость исследования — от 300 €, в зависимости от площади и количества обследуемых зон.
Срок выполнения — 5–14 дней, включая лабораторные анализы.
❗ Важно: при необходимости мы предоставляем официальное заключение для суда, управляющих компаний и страховых организаций.
Свяжитесь с нами — поможем навсегда избавиться от плесени и защитим ваше здоровье!
